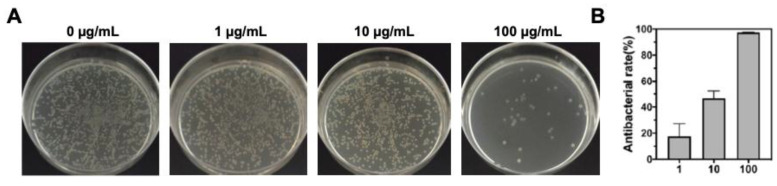

Erratum: An electroporation strategy to synthesize the membrane-coated nanoparticles for enhanced anti-inflammation therapy in bone infection: Erratum.
IF 13.3
1区 医学
Q1 MEDICINE, RESEARCH & EXPERIMENTAL
引用次数: 0
Abstract
[This corrects the article DOI: 10.7150/thno.48407.].
一个电穿孔策略合成膜包覆纳米颗粒增强抗炎症治疗骨感染:勘误。
[这更正了文章DOI: 10.7150/thno.48407.]。
本文章由计算机程序翻译,如有差异,请以英文原文为准。
求助全文
约1分钟内获得全文
求助全文
来源期刊

Theranostics
MEDICINE, RESEARCH & EXPERIMENTAL-
CiteScore
25.40
自引率
1.60%
发文量
433
审稿时长
1 months
期刊介绍:
Theranostics serves as a pivotal platform for the exchange of clinical and scientific insights within the diagnostic and therapeutic molecular and nanomedicine community, along with allied professions engaged in integrating molecular imaging and therapy. As a multidisciplinary journal, Theranostics showcases innovative research articles spanning fields such as in vitro diagnostics and prognostics, in vivo molecular imaging, molecular therapeutics, image-guided therapy, biosensor technology, nanobiosensors, bioelectronics, system biology, translational medicine, point-of-care applications, and personalized medicine. Encouraging a broad spectrum of biomedical research with potential theranostic applications, the journal rigorously peer-reviews primary research, alongside publishing reviews, news, and commentary that aim to bridge the gap between the laboratory, clinic, and biotechnology industries.
 求助内容:
求助内容: 应助结果提醒方式:
应助结果提醒方式:


